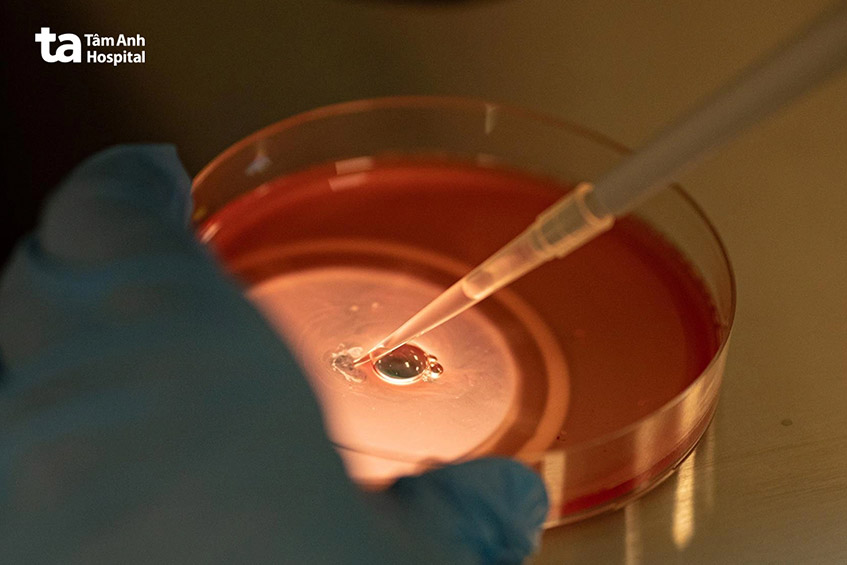
trứng được chọc hút chuyển vào phòng thí nghiệm

Với thành công trong công nghệ trữ trứng đã tạo ra tiền đề và động lực cho các ngân hàng trứng trên thế giới phát triển. Vậy ngân hàng trứng là gì? Ngân hàng trứng ở Việt Nam có hay không? Bài viết này sẽ cung cấp về những thông tin về mô hình và cách hoạt động của ngân hàng trứng.

Bác sĩ Phạm Thị Mỹ Tú, Trung tâm Hỗ trợ sinh sản, BVĐK TP.HCM cho biết “Hiện nay Tại Việt Nam cũng như nhiều nước trên thế giới chưa triển khai thành lập ngân hàng trứng. Việc kích trứng, chọc hút trứng và bảo quản trứng là một quy trình can thiệp sâu với chi phí cao.
Tại IVFTA-HCM chúng tôi hiểu có con và được ôm con vào lòng chính là điều ước thiêng và khát khao của nhiều cặp vợ chồng vô sinh hiếm muộn. Vì vậy, đội ngũ chuyên gia tại IVFTA-HCMC luôn cố gắng chắt chiu những cơ hội dù là nhỏ nhất để mở ra những cánh cửa hy vọng cho các cặp vợ chồng vô sinh hiếm muộn có thể sinh con chính chủ mà không phải đối diện với các giải pháp như mang thai hộ, xin trứng hay xin tinh trùng.”
Ngân hàng trứng hiến tặng khá giống với ngân hàng tinh trùng. Nếu ai đó muốn hiến tặng trứng, họ có thể liên hệ với ngân hàng trứng. Ngân hàng trứng sẽ tiếp nhận hồ sơ sau đó thực hiện nhiều cuộc sàng lọc để xem xét liệu cá nhân đó có phù hợp để hiến tặng trứng hay không.
Dù muốn hay không thì mỗi tháng vẫn có hàng trăm đến hàng ngàn tế bào từ hai buồng trứng được huy động và tự thoái hoá theo sinh lý. Chỉ cần một số nhỏ trong đó có thể tạo ra một cuộc sống mới, thắp lên hy vọng cho cho không chỉ một người mà lớn hơn là một gia đình, một dòng tộc. Việc hiến tặng trứng được xem là một nghĩa cử cao đẹp mà đầy tính nhân văn.
Chúng ta nghe nhiều về ngân hàng tinh trùng, ngân hàng máu nhưng ngân hàng trứng vẫn là cụm từ khá xa lạ với nhiều người. Vậy chức năng của ngân hàng trứng là gì? Với sự phát triển của kỹ thuật trữ đông trứng hiện nay, có nhiều ngân hàng trứng đã được thành lập và vận hành ở một vài quốc gia trên thế giới. Việc hiến tặng trứng vào ngân hàng trứng đóng vai trò quan trọng trong việc giúp đỡ những cặp vợ chồng hiếm muộn có thể mang thai và có con trong tương lai.
Ngân hàng trứng cũng đang được nghiên cứu như một hình thức để bảo tồn khả năng sinh sản nữ giới. Điều này sẽ hữu ích cho những phụ nữ bị mắc các bệnh lý như ung thư muốn có con sau hóa trị, xạ trị hoặc một số loại phẫu thuật có thể gây vô sinh.
Ngân hàng trứng được áp dụng cho những đối tượng nào là vấn đề mà nhiều người quan tâm. Chúng ta biết rằng việc lập gia đình, có con là ước mơ của đa số các cặp vợ chồng. Tuy nhiên không phải gia đình nào cũng có thể thuận lợi thực hiện giấc mơ này.
Ngân hàng trứng được thành lập để cung cấp cho những phụ nữ không còn sản xuất hoặc không thể sử dụng trứng của chính bản thân để mang thai và sinh con. Những trứng được hiến tặng có thể được sử dụng trong kỹ thuật thụ tinh trong ống nghiệm và mang thai để giúp các cá nhân có thể đạt được ước mơ làm cha mẹ.
Nguyên nhân hiếm muộn có thể đến từ hai phía vợ và chồng. Về phía người phụ nữ, vấn đề về suy giảm chức năng buồng trứng, bệnh lý về buồng trứng, bất thường về di truyền làm cho buồng trứng bị suy giảm nhanh hơn bình thường. Nhiều phụ nữ đối mặt với nguy cơ hết trứng sớm, thậm chí không thể mang thai bằng chính trứng của mình. Vì vậy nhiều người tìm hiểu các thông tin về ngân hàng trứng để có thể mang thai và sinh con với trứng được nhận từ ngân hàng trứng.

Người muốn hiến tặng trứng vào ngân hàng phải trải qua quy trình sàng lọc nghiêm ngặt trước khi hiến tặng. Việc sàng lọc bao gồm các đánh giá về y tế để xác định người hiến trứng tiềm năng khỏe mạnh, cũng như các xét nghiệm để loại trừ các bệnh truyền nhiễm như giang mai, HIV, viêm gan siêu vi B. Ngân hàng trứng cũng sẽ đánh giá các thông tin sức khỏe tiềm ẩn có thể ảnh hưởng đến em bé trong tương lai chẳng hạn như tiền sử bệnh lý gia đình hoặc dị tật bẩm sinh di truyền.
Cuối cùng, những người hiến trứng có tiềm năng sẽ được trải qua một cuộc đánh giá tâm lý. Sau khi một người hiến trứng tiềm năng vượt qua các bài kiểm tra, ngân hàng trứng của người hiến tặng thường chi trả các chi phí lấy trứng. Chi phí này bao gồm các loại thuốc tiêm trong quá trình kích thích buồng trứng, chi phí chọc hút trứng và đông lạnh trứng.
Sau đó, ngân hàng trứng của người hiến sẽ bổ sung thông tin của người hiến trứng vào trang thông tin của họ để các cặp vợ chồng hoặc người có nhu cầu xem xét. Các thông tin đó thường bao gồm như trình độ học vấn, tiền sử sức khỏe và thậm chí là ảnh của người hiến tặng.
Thông thường khi nhận trứng từ ngân hàng trứng, người nhận trứng không có hợp đồng pháp lý với người hiến tặng. Thay vào đó các ngân hàng trứng thường ký hợp đồng riêng với người hiến trứng. Sau đó người có nhu cầu sử dụng trứng từ ngân hàng sẽ ký một hợp đồng riêng với ngân hàng trứng khi họ chọn trứng.
Vì trứng đã được thu thập và trữ lạnh trứng nên việc sử dụng trứng từ ngân hàng có thể làm giảm thời gian điều trị cho những cặp vợ chồng vì họ không phải chờ lấy trứng.
Trước những lợi ích ngân hàng trứng đem lại, nhiều chị em thắc mắc ở Bệnh viện Đa khoa Tâm Anh có ngân hàng trứng không hay ngân hàng trứng ở Việt Nam có không. Như đã đề cập ở trên, tại Việt Nam và nhiều nước trên thế giới ngân hàng trứng vẫn chưa được triển khai vì việc trữ trứng đòi hỏi những điều kiện rất ngặt nghèo.
So với ngân hàng tinh trùng, ngân hàng trứng có điều kiện thành lập phức tạp hơn như người phụ nữ phải đảm bảo được các điều kiện của người hiến trứng, người hiến trứng phải tiêm thuốc kích trứng, gây mê, tiến hành chọc hút trứng và trữ trứng. Tuy nhiên tế bào trứng được xem là tế bào khó trữ lạnh nhất vì vậy hiện nay tại Việt Nam chỉ có ít trung tâm có thể đủ điều kiện để có thể tiến hành trữ trứng.
Theo bác sĩ Phạm Thị Mỹ Tú ”Mặc dù chưa có ngân hàng trứng nhưng IVFTA-HCM đã làm chủ được công nghệ trữ rã trứng, đây được xem là một “đặc sản” của IVFTA-HCM.”
Tại IVFTA-HCM theo thống kê từ năm 2022 thì 50% các ca chọc hút trứng mỗi ngày là các ca trữ trứng. Đây là tín hiệu hết sức đáng mừng vì kỹ thuật trữ rã trứng tại IVFTA đã được hoàn thiện và mang đến nhiều lợi ích to lớn.
Theo ThS.BS Giang Huỳnh Như – Giám đốc trung tâm Hỗ trợ sinh sản, BVĐK Tâm Anh TP.HCM cho biết “Trước đây, xin trứng là chỉ định bác sĩ hay nhắc đến với nhóm bệnh nhân có dự trữ buồng trứng thấp. Tôi nhớ có một báo cáo trên một tạp chí lớn năm 2019 đưa ra một con số là amh dưới 0,7 có khả năng chọc hút không trứng hoặc không phôi. Tôi thấy trong năm 2022 thì nó dường như không đúng nữa, như tôi nói 50% số ca chọc hút noãn mỗi ngày đó là trữ noãn, trong đó có ⅘ trường hợp trữ noãn vì dự trữ buồng trứng thấp.”
Trước đây trong điều trị thụ tinh ống nghiệm cần trung bình 10 trứng thì giờ tại IVFTA cần 6-7 trứng thì có thể làm ít nhất cho bệnh nhân 1 phôi ngày 5. Giả sử với bệnh nhân amh thấp, 1 lần lấy 2-3 trứng thì cần 3 lần lấy trứng, chúng ta có số lượng trứng mong đợi để có được ít nhất 1 phôi ngày 5. Mục tiêu cuối có số lượng trứng tối ưu để người bệnh có được 1-2 phôi ngày 5, từ đó giúp 70% phụ nữ từng có chỉ định xin noãn có thể có con chính chủ.
Vì vậy với những trường hợp phụ nữ có dự trữ buồng trứng thấp hoặc từng có chỉ định xin trứng đừng vội từ bỏ hy vọng. Bạn có thể đến IVFTA-HCM để được các bác sĩ thăm khám và lên kế hoạch điều trị cụ thể.
Trung tâm Hỗ trợ sinh sản Bệnh viện Đa khoa Tâm Anh quy tụ đội ngũ y bác sĩ là những chuyên gia giàu kinh nghiệm trong lĩnh vực điều trị vô sinh hiếm muộn, sở hữu hệ thống máy móc, trang thiết bị hiện đại, hệ thống phòng Lab siêu sạch đạt tiêu chuẩn ISO 5 nghiêm ngặt… triển khai đa dạng tất cả các kỹ thuật hỗ trợ sinh sản tiên tiến nhất hiện nay, hiện thực hóa ước mơ bồng bế con yêu “chính chủ” của hàng triệu cặp vợ chồng hiếm muộn.
Tại Trung tâm Hỗ trợ sinh sản BVĐK Tâm Anh có nhiều phương pháp hỗ trợ sinh sản như:
Để nâng cao tỷ lệ thành công trong điều trị hiếm muộn, bên cạnh đội ngũ chuyên gia/bác sĩ giàu kinh nghiệm, phòng LAB đạt chuẩn quốc tế, trang thiết bị hiện đại, IVFTA cũng thường xuyên cập nhật kỹ thuật mới/ tiên tiến nhất trên thế giới. Cụ thể:

Để được tư vấn và hướng dẫn các bước chuẩn bị cho quá trình điều trị hiếm muộn với các chuyên gia giàu kinh nghiệm tại Trung tâm Hỗ trợ sinh sản Bệnh viện Đa khoa Tâm Anh, quý khách hàng vui lòng liên hệ đến:
HỆ THỐNG BỆNH VIỆN ĐA KHOA TÂM ANH
Trên đây là những thông tin về ngân hàng trứng và cách thức vận hành của ngân hàng trứng. Đội ngũ chuyên gia tại IVFTA-HCM thấu hiểu lựa chọn về xin trứng hay ngân hàng trứng là bước cứu cánh cuối cùng cho nỗ lực làm mẹ của người phụ nữ. Tại IVFTA-HCM trước khi đưa ra quyết định xin trứng, chúng tôi luôn cố gắng tối đa bằng cách nâng cao trình độ chuyên môn và đầu tư thiết bị hiện đại tận dụng tối đa cơ hội mang thai và sinh con bằng chính noãn của mình, điều quan trọng chị em nên thăm khám sớm để được các bác sĩ lên phác đồ và điều trị hiệu quả nhất.